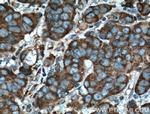
DHCR24 Antibody in Immunohistochemistry (Paraffin) (IHC (P))

Search
Proteintech
DHCR24 Monoclonal Antibody (2F6E11)
{{$productOrderCtrl.translations['antibody.pdp.commerceCard.promotion.promotions']}}
{{$productOrderCtrl.translations['antibody.pdp.commerceCard.promotion.viewpromo']}}
{{$productOrderCtrl.translations['antibody.pdp.commerceCard.promotion.promocode']}}: {{promo.promoCode}} {{promo.promoTitle}} {{promo.promoDescription}}. {{$productOrderCtrl.translations['antibody.pdp.commerceCard.promotion.learnmore']}}
产品信息
60028-1-IG
种属反应
宿主/亚型
分类
类型
克隆号
抗原
偶联物
形式
浓度
纯化类型
保存液
内含物
保存条件
运输条件
产品详细信息
Aliquoting is unnecessary for -20°C storage.
靶标信息
DHCR24 is a flavin adenine dinucleotide (FAD)-dependent oxidoreductase which catalyzes the reduction of the delta-24 double bond of sterol intermediates during cholesterol biosynthesis. This protein contains a leader sequence that directs it to the endoplasmic reticulum membrane. Missense mutations in this gene have been associated with desmosterolosis. Also, reduced expression of its gene occurs in the temporal cortex of Alzheimer disease patients and overexpression has been observed in adrenal gland cancer cells.
仅用于科研。不用于诊断过程。未经明确授权不得转售。
篇参考文献 (0)
生物信息学
蛋白别名: 24-dehydrocholesterol reductase; 3 beta-hydroxysterol delta 24-reductase; 3-beta-hydroxysterol Delta-24-reductase; Delta(24)-sterol reductase; desmosterol-to-cholesterol enzyme; Diminuto/dwarf1 homolog; seladin 1; Seladin-1; selective AD indicator 1
基因别名: DCE; DHCR24; KIAA0018; Nbla03646; seladin-1; SELADIN1
UniProt ID: (Human) Q15392
Entrez Gene ID: (Human) 1718